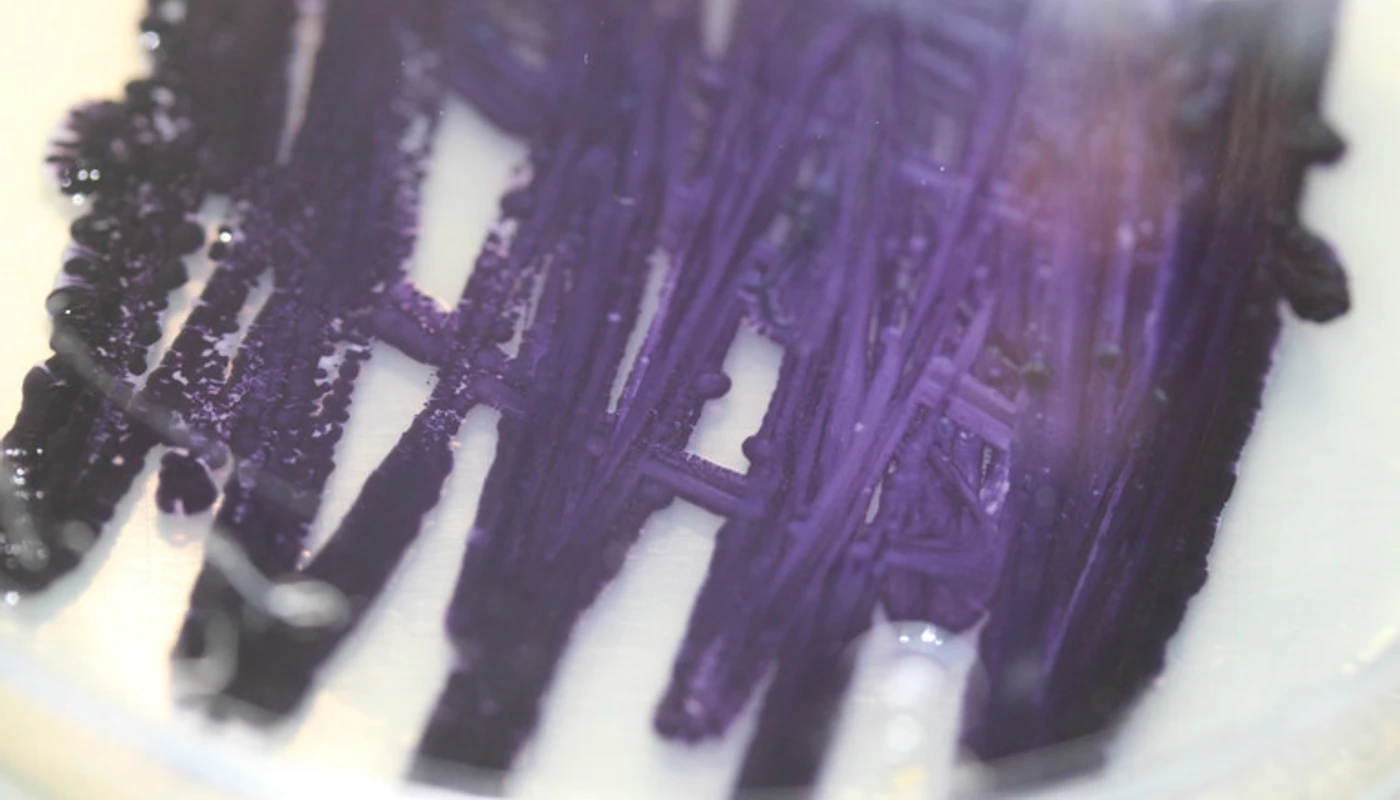

The purple pigment producing bacteria Janthinobacterium Lividum.
Co-Cultivating Colours
- Ph.d. studerende
-
Monica Louise Hartvigsen
- Hovedvejleder
- Karen Marie Hasling
- Projektvejleder
- Vibeke Riisberg
- LAB
- LAB for Bæredygtighed og Design
- LAB tema
- Material Life
- Samarbejdspartnere
- Kvadrat
- Eksterne links
- PURE
About
The PhD project explores alternative ways to work with colour and materials by ‘co-cultivating’ with living microorganisms. Material experiments are conducted, to explore aesthetic and technical properties of bacterial and fungal colours by merging biology and design in a ‘Do It Yourself’ (DIY) laboratory at Kolding School of Design as well as in more advanced laboratories at other institutions.
In addition, educational material will be developed to test if design students can navigate in a DIY lab, thus uncovering how living microorganisms could be integrated in design education.

Looking for microorganisms by taking small samples from nature.
Methods and outcome
Methods
The PhD project is a strongly connected with design practice and thus uses a practice-led research approach, where a Research Through Design (RTD) methodology is applied.
The design program is a core method and provides an overall frame for the individual design experiments and allows for an iterative exploration using prototyping as way to create knowledge. In addition, some methods from biology will be applied i.e., growing the microorganisms and producing pigment drawing upon my knowledge from previous studies in molecular biology.
Expected outcome
The project contributes with both practical and academic knowledge. Hopefully the explorations will lead to insights relevant to design research and education, but also for the textile industry, since microbes can potentially change the way, we produce and use colour. A big part of the project is carried out in different laboratory settings as the ‘field of inquiry’, thus exploring how designers engage in different laboratory practices.

The purple pigment producing bacteria Janthinobacterium Lividum.